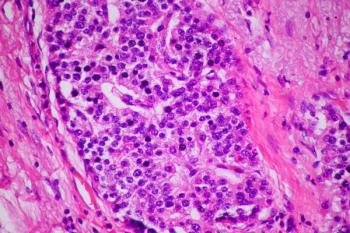

Pharmaceutical Commerce Editorial Staff
Articles by Pharmaceutical Commerce Editorial Staff

Today's approval amends the accelerated approval granted by the FDA in April 2019 to Balversa (erdafitinib) for patients with metastatic urothelial carcinoma with susceptible FGFR2 or FGFR3 alterations following prior treatment with platinum-containing chemotherapy.

Data presented at the 2024 American Society of Clinical Oncology Gastrointestinal Cancers Symposium show first-line Lutathera plus long-acting release octreotide lowered the risk of disease progression or death by 72% in patients with advanced gastroenteropancreatic neuroendocrine tumors.

Application seeks approval for tumor-treating fields therapy combined with either an immune checkpoint inhibitor or docetaxel in patients with metastatic non-small cell lung cancer following progression on or after the use of platinum-based therapy.

Data show daily oral dosing of NX-5948 in patients with relapsed or refractory B-cell malignancies experienced a clinical benefit across dose ranges from 50 mg to 200 mg.

The predicted value is largely driven by manufacturers' prioritization of brand protection.

EdenHelp is expected to provide HCPs and patients with real-time access to Rx drug and medical device information.

Patients with chronic inflammatory demyelinating polyneuropathy administered HyQvia showed a statistically significant difference between relapse rates compared with placebo.

Analysis examines how social and healthcare factors play a role.

Initiative seeks to find new therapies to improve the lives of patients with Rett syndrome.

The list price of Casgevy for transfusion-dependent beta thalassemia has yet to be released, however, the cost for the treatment in sickle cell disease is $2.2 million.

Trial shows 52% of patients with atopic dermatitis with uncontrolled moderate-to-severe hand and/or foot involvement administered Dupixent experienced a clinically meaningful reduction in itch on hands and feet vs. 14% with placebo.

IATA’s latest numbers suggest the strongest year-on-year growth in almost two years.

FDA approves Keytruda (pembrolizumab) combined with chemoradiation for the treatment of patients with FIGO 2014 stage III to IVA cervical cancer, which is the 39th overall approved indication for the drug in the United States.

The group—known as the Innovators' Network—is meant to serve as a link between entrepreneurs, providers, researchers, and payers while they strive to combat cardiovascular disease.

RemeGen Co. Ltd’s antibody-drug conjugate RC88 is being analyzed to treat platinum-resistant recurrent epithelial ovarian, fallopian tube, and primary peritoneal cancer.

The US Department of Defense awarded Emergent BioSolutions Inc. with a contract worth up to $235.8 million to supply all branches of the US military with BioThrax (Anthrax Vaccine Adsorbed) for use as pre-exposure prophylaxis against anthrax disease.

Axon Therapy is a noninvasive system that sends magnetic pulses through the skin that stimulate damaged peripheral nerve cells involved in the body’s pain relief mechanism.
Lutathera is indicated for patients with somatostatin receptor–positive gastroenteropancreatic neuroendocrine tumors (GEP-NETs), including foregut, midgut, and hindgut NETs.

SELLAS Life Sciences Group, Inc’s CDK9 inhibitor SLS009 is being evaluated in combination with Venclexta (venetoclax) and Vidaza (azacytidine) for patients with relapsed or refractory acute myeloid leukemia.

The novel therapy in development to treat breast cancer and ovarian cancer is a formulation of a well-established freeze-dried powder medication that has been in use dating back to the 1950s.

Acquisition is expected to offer life sciences clients a boost in expertise and insight.

At the 42nd annual JP Morgan Healthcare Conference, Moderna said new product launches later this year will return the company to sales growth in 2025.

Lutikizumab is an investigational, dual-variable-domain IL 1α/1β antagonist to Phase III for the treatment of hidradenitis suppurativa.

Astellas said it will work closely with the FDA and a third-party manufacturer to develop a timeline that will quickly resolve feedback from the complete response letter to a Biologics License Application for zolbetuximab.

Tivdak (tisotumab vedotin-tftv), an antibody drug conjugate, was granted accelerated approval by the FDA in September 2021 for patients with recurrent or metastatic cervical cancer with disease progression on or after first-line therapy.

Rinatabart sesutecan (Rina-S; PRO1184) showed encouraging antitumor activity and tolerability in patients with FRα-expressing high-grade serous or endometrioid platinum-resistant ovarian cancer.

Scemblix (asciminib) was approved by the FDA in October 2021 for patients with chronic phase chronic myeloid leukemia previously administered two or more tyrosine kinase inhibitors and for adults with chronic phase chronic myeloid leukemia with the T315I mutation.

In the midst of being approved for commercial manufacturing of Pluvict, the 70,000 square-foot site was built specifically to accommodate RLT production.

Trials will evaluate four novel agents for cancers that include essential thrombocythemia, chronic lymphocytic leukemia, small lymphocytic lymphoma, non-small cell lung cancer, endometrial carcinoma, and metastatic castration-resistant prostate cancer.

US biosimilars market projected to grow from less than $10 billion in 2022 to more than $100 billion by 2029.